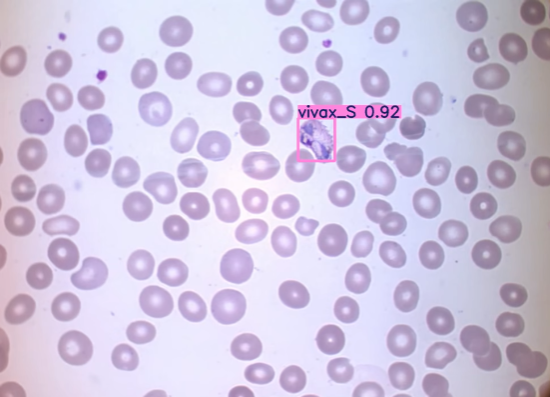
Automated Malaria Detection: CDC Guidelines, Malaria Parasite & AI

Tutorials
-
Architecture & Infrastructure for Financial AI, Synthetic Data & Machine Learning Foundations, Tutorials, USE CASE
Architecture & Infrastructure for Financial AI, Synthetic Data & Machine Learning Foundations, Tutorials, USE CASEAutomated Malaria Detection: CDC Guidelines, Malaria Parasite & AI
AI Diagnostics · Global Health · Northhaven Analytics Automated Malaria Detection: How Computer Vision Identifies…
-

Autonomous SME Credit Scoring Engine | Northhaven Analytics
● ENGINE LIVE SME Credit Scoring · Predictive Underwriting The Dawn ofPredictive Underwriting Northhaven Analytics…
-

Northhaven x Coloplast: AI in Ostomy Care | Case Study
MedTech · SaMD · AI · Coloplast Heylo How Northhaven Analytics is Revolutionizing Ostomy Care…
-

Northhaven x Coloplast: AI w Opiece Stomijnej | Case Study
MedTech · SaMD · AI · Coloplast Heylo Jak Northhaven Analytics rewolucjonizuje opiekę stomijną dzięki…
-

Northhaven Hub: The Ultimate Synthetic Data Platform
Northhaven Hub — The End of Waiting Northhaven Hub · Product Launch The End of…
-

Northhaven Hub: Platforma Danych Syntetycznych
Northhaven Hub — Koniec z czekaniem Northhaven Hub · Product Launch Koniec z czekaniem.Deep Tech…
-

Credit Risk Scoring Guide: How to Assess Creditworthiness in 3 Minutes with AI | Northhaven Analytics
Credit Risk Scoring Guide: How to Assess Creditworthiness in 3 Minutes with AI | Northhaven…
-

Northhaven Eyo: Automatyczna Analiza Wyciągów Bankowych z ML
Credit Risk Scoring — Przewodnik użytkownika | Northhaven Analytics Tutorial · Platforma Credit Risk Scoring…